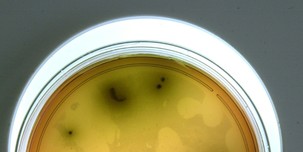

Top News
Lokales

Schäffler, Schaumkronen und schallendes Gelächter
Wenn sich nur alle sieben Jahre die Reif...
Es ist ein Schauspiel, das man nicht jedes Jahr erlebt. Nur alle sieben Jahre ziehen die Schäff...



Entertainment

Mutmaßliches Vergewaltigungsopfer von Mette-Marits...
Im Vergewaltigungsprozess gegen den Sohn von Norwegens Kronprinzessin Mette-Marit hat eine drit...



Technik

Bundeskabinett befasst sich mit EU-Regeln für Küns...
Das Bundeskabinett befasst sich am Mittwoch mit der EU-weiten Regulierung der Künstlichen Intel...



Wirtschaft & Politik

Dröge: Reiche will Energiewende und Bürgerenergie...
Grünen-Fraktionschefin Katharina Dröge sieht in den Gesetzesplänen von Bundeswirtschaftsministe...

Fitness & Gesundheit

Olympische Winterspiele in Italien: Bereits 10.000...
In der ersten Woche der Olympischen Winterspiele in Italien sind bereits 10.000 Kondome ausgege...



Sport

2:1 gegen St. Pauli trotz Witz-Elfer: FCA holt wic...
Augsburg dreht Spiel dank Doppelpacker G...
"A day to remember" – davon hatte FCA-Trainer Manuel Baum vor dem Spiel gegen den Rekordmeister...



Start-Up

Startup des Monats: änny – Das LernSpielMöbel
ännyThing is possible!
Das Herzensprojekt änny, entstand im Jahr 2020 von Alina Gaidies. Die Idee, Kindern mehr Freira...



Freizeit

Den Stars und Sternchen so nah mit Jana: Saxophoni...
Zwischen Brooklyn und Berlin
Tobias Meinhart zählt zu den markantesten Größen des modernen Jazz – ein Saxophonist, der mit s...



Auto

Was ist die THG-Quote? Wie Elektroautos Geld einbr...
Im Jahr 2026 sollen für Elektroauto-Besi...
Die THG-Quote gehört seit einigen Jahren zu den Mechanismen, mit denen der Verkehrssektor klima...



Fashion

Modetrends 2026 – Zwischen Klarheit, Komfort und i...
Frühling im Kleiderschrank
Ein Blick auf die Modetrends 2026 zeigt, welche Looks die Vorfreude auf das Frühjahr wecken. Di...



Wie stylt man Stiefeletten in Herbstoutfits?
Genuss

Food-Trends 2026: Nachhaltig, gesund und kreativ –...
Genuss mit Haltung
Wie wird in Zukunft gegessen – bewusster, bequemer oder ganz neu gedacht? Welche Zutaten landen...



Liebe & Leidenschaft

Der Valentinstag: Zwischen großen Gesten und klein...
Jetzt geht es um die Liebe!
Der Valentinstag polarisiert. Während ihn die einen als romantischen Höhepunkt im Kalender betr...



Leben & Wohnen

Bald erwacht der Frühling! Mit Zwiebelpflanzen sch...
Bunte Blüten wecken Vorfreude
Auch wenn es draußen noch winterlich ist, wächst bei vielen bereits die Sehnsucht nach dem Früh...



Familie

Die fünfte Jahreszeit lässt grüßen! Wissenswertes,...
Zwischen Konfetti, Krapfen und Karneval
Wenn im Februar Konfetti durch die Straßen wirbelt, fantasievolle Kostüme Blicke auf sich ziehe...



Beruf & Karriere

Brückentage 2026: So holen Arbeitnehmer die meiste...
Nicht alle Feiertage liegen perfekt
Mit einem guten Blick auf die Feiertage können Arbeitnehmer das Beste aus ihrem Urlaub herausho...



Fun

TRENDYONEBRAINIAC JANUAR 2026
Hier ist die Lösung...
„Das Rätsel ist eine Aufgabe, die durch Denken gelöst werden muss“. Ganz nach diesem Motto biet...



Gewinnspiele

Großes Europa-Park Gewinnspiel! Jetzt teilnehmen u...
Viel Glück!
Der SC Freiburg trägt seine Heimspiele im „Europa-Park Stadion“ aus. Deutschlands größter Freiz...



